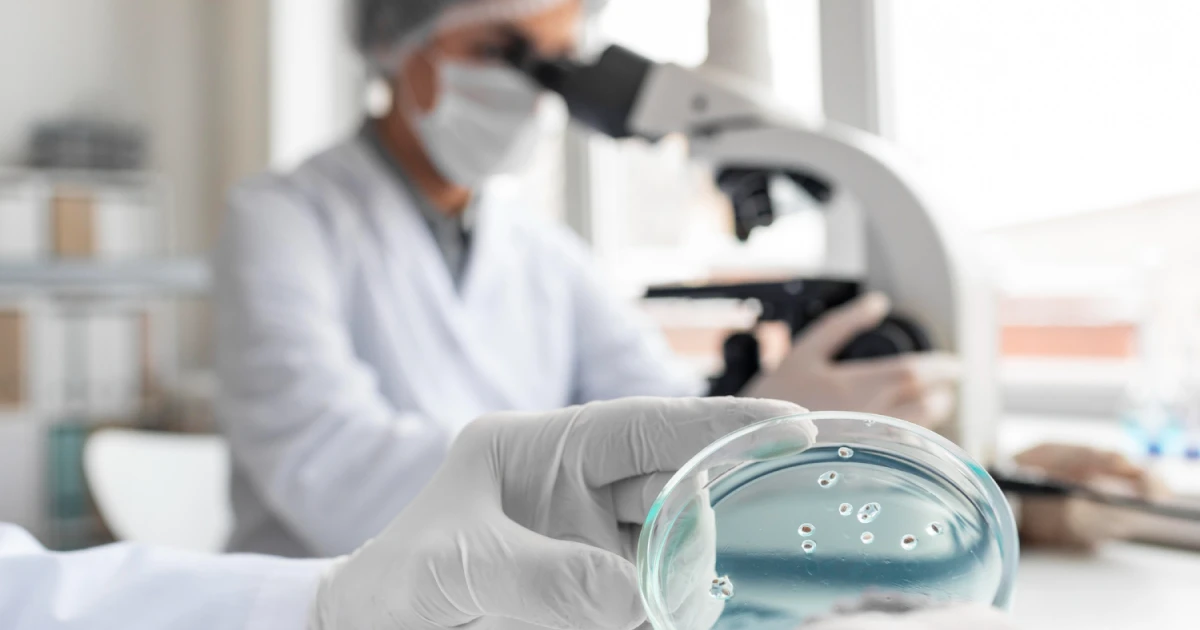
PLM centralisant les données produit, formulation et conformité réglementaire dans un laboratoire industriel

Comment le plm favorise l’innovation industrielle sans compromettre la conformité
Publié le 2025-11-18

Dans un contexte industriel marqué par la pression réglementaire, la volatilité des marchés et l’accélération des cycles de développement, les entreprises doivent résoudre une équation complexe : innover vite sans compromettre la conformité. Le PLM (Product Lifecycle Management) s’impose aujourd’hui comme un levier stratégique pour maîtriser cette équation.
Mais sa véritable puissance se révèle lorsqu’il est intégré à l’ERP (planification & ressources) et à la GPAO (Gestion de Production Assistée par Ordinateur), permettant une synchronisation fluide entre conception, planification et exécution industrielle.
Ce blog détaille comment le PLM stimule l’innovation, sécurise la conformité, et comment son intégration avec l’ERP et la GPAO crée une chaîne digitale unifiée, fiable et performante.
Pourquoi le PLM est essentiel pour innover en maîtrisant les risques ?
L’innovation industrielle n’est plus seulement une question de créativité : elle dépend de la capacité à concevoir, tester, valider et produire des produits sans erreurs, sans ruptures d’informations et sans non-conformités.
Le PLM centralise et structure tout le cycle de vie du produit, de l’idée initiale jusqu’à la mise sur le marché.
Une seule source de vérité pour la R&D
Le PLM centralise toutes les données produit dans un référentiel unique : formulations, plans, nomenclatures, propriétés physico-chimiques, documents qualité, exigences clients et contraintes réglementaires. Cette unification élimine les dispersions d’informations, souvent causes de retards ou de non-conformités. Les équipes R&D travaillent ainsi sur des données fiables, actualisées et validées, ce qui améliore considérablement la qualité du processus de conception.
Innovation accélérée grâce au contrôle des versions
Grâce au contrôle strict des versions et aux workflows de validation intégrés, le PLM permet de gérer des scénarios multiples : variantes produit, prototypes, évolutions réglementaires, reformulations, etc. Chaque modification est tracée, historisée et analysée. Cela permet aux entreprises d’innover plus rapidement, car elles peuvent tester différentes options sans perdre le contrôle ou risquer une dérive non conforme. L’innovation devient structurée plutôt que chaotique.
Conformité intégrée dès la conception (Design-to-Compliance)
Le PLM intègre les règles et contraintes réglementaires dès les premières étapes de développement. Que ce soit REACH, CLP, ISO, GMP, FDA ou des normes spécifiques, le système vérifie automatiquement les compatibilités, restrictions ou limites. Cette approche “Design-to-Compliance” évite les reformulations tardives — souvent coûteuses et risquées — et garantit que chaque nouveauté produit respecte les exigences légales avant même l’industrialisation.
L’intégration PLM + ERP : transformer l’innovation en production maîtrisée
L’innovation n’a de valeur que si elle peut être industrialisée rapidement et sans erreur. C’est là qu’intervient l’intégration forte entre le PLM et l’ERP. Le PLM gère le produit ; l’ERP gère l’entreprise. Ensemble, ils créent une continuité numérique qui élimine les ressaisies manuales et les incohérences.
Transfert automatique des données produit validées
Lorsque la R&D valide une formulation, une nomenclature ou un paramètre produit dans le PLM, ces informations sont automatiquement envoyées à l’ERP. Cela inclut les quantités, les matières premières, les unités de mesure, les spécifications et même les coûts prévisionnels. Ce transfert automatisé élimine les erreurs humaines et garantit que la production et les achats utilisent toujours les données officielles et validées.
Alignement entre R&D, Achats et Production
Avec l'intégration PLM-ERP, toutes les équipes bénéficient d’une cohérence parfaite. Les achats savent exactement quelles matières premières sont autorisées et validées, et peuvent anticiper les besoins. La planification construit des ordres de fabrication fiables, basés sur les données réelles produit. La production exécute sans ambiguïté. Cet alignement réduit considérablement les retards de mise en production et élimine les interprétations erronées.
Maîtrise du coût du produit (Cost-Driven Design)
Le PLM aide à simuler différentes versions produit, tandis que l’ERP fournit les données économiques réelles (prix matières, main-d'œuvre, énergie, consommables…). Ensemble, ils permettent à la R&D d’intégrer le coût comme critère dès la conception. Cela conduit à des produits plus compétitifs, sans sacrifier la conformité ou la qualité. Les arbitrages se font plus tôt, évitant des reconceptions tardives coûteuses.
Intégration PLM + GPAO : relier la conception aux opérations de production

La GPAO (Gestion de Production Assistée par Ordinateur) représente le cœur opérationnel de la fabrication industrielle. En la connectant au PLM, les entreprises assurent que les instructions de production, les recettes et les paramètres de process reflètent parfaitement les données validées par la R&D.
Instructions de fabrication directement issues du PLM
Les données envoyées par le PLM à la GPAO incluent les recettes, les listes de composants, les paramètres de machine, les gammes opératoires et les contrôles qualité nécessaires. La GPAO utilise ces données pour générer les ordres de fabrication exacts, sans risque de mauvaise interprétation. La production s’exécute sur des instructions validées, cohérentes et toujours à jour, ce qui améliore la qualité finale et réduit les rebuts.
Traçabilité complète du lot jusqu’à la formulation
Grâce à la connexion PLM-GPAO, chaque lot produit peut être relié à sa version de formulation, à ses matières premières, à ses conditions de production et à ses paramètres de process. Cette traçabilité complète est essentielle pour les audits, les enquêtes sur la qualité et les obligations réglementaires. L’entreprise peut démontrer précisément comment un produit a été fabriqué, en utilisant quelles données, et selon quelles validations.
Mise à jour instantanée en cas de changement de version
Quand un produit évolue — changement d’ingrédient, nouvelle formulation, mise à jour réglementaire ou amélioration du process — la GPAO est automatiquement synchronisée. Les opérateurs disposent immédiatement des nouvelles instructions. Cela évite les fabrications avec des versions obsolètes et réduit les risques de non-conformité ou de rappel produit. La chaîne conception-production devient pleinement agile.
Innovation, conformité et performance : la puissance de la chaîne PLM → ERP → GPAO

L’intégration complète des trois systèmes crée un environnement numérique fluide, structuré et fiable. Cette continuité apporte une maîtrise totale des données et des processus, permettant aux entreprises innovantes d’industrialiser plus rapidement et plus sereinement.
Un flux logique et fluide
Le flux PLM → ERP → GPAO garantit une cohérence totale entre les étapes de conception, de planification et d’exécution. Le PLM fournit les données produit, l’ERP gère les ressources et la planification, tandis que la GPAO exécute la production selon les paramètres validés. Cette continuité élimine les ruptures d’information et les erreurs de ressaisie, tout en améliorant la réactivité industrielle.
Réduction massive des risques de non-conformité
La conformité est assurée dès la conception grâce au PLM. Elle est renforcée par la planification rigoureuse de l’ERP et consolidée par la traçabilité de la GPAO. Cette combinaison réduit drastiquement les risques d’audit défavorable, de non-conformité réglementaire ou de rappel produit. Les entreprises peuvent lancer des innovations plus rapidement, tout en respectant les normes les plus strictes.
Innovation accélérée et industrialisation plus rapide
En éliminant les silos entre les départements et en assurant une cohérence parfaite des données, la chaîne PLM-ERP-GPAO raccourcit les délais de développement et de mise sur le marché. Les équipes collaborent mieux, les décisions sont prises plus rapidement, et les innovations sont industrialisées avec moins de risques. L’entreprise gagne en agilité, en compétitivité et en qualité.
Cas d’usage concrets : une valeur ajoutée pour toutes les industries
L’intégration PLM → ERP → GPAO crée une chaîne numérique cohérente qui s’adapte à tous les environnements industriels, qu’ils soient fortement réglementés, très techniques ou orientés performance. Voici comment ce triptyque digital répond aux exigences spécifiques de chaque secteur.
Industrie pharmaceutique: Formulation sûre, stable, efficace et conforme.
Dans l’industrie pharmaceutique, où la qualité et la conformité sont non négociables, le PLM joue un rôle déterminant. Il centralise les données de formulation, gère les versions et garantit la cohérence documentaire nécessaire aux audits GMP et FDA. L’ERP assure la disponibilité des matières premières validées et la gestion stricte des lots, tandis que la GPAO exécute les ordres de fabrication selon les protocoles validés, garantissant stabilité, efficacité et reproductibilité des médicaments. Le triptyque digital sécurise toute la chaîne, de la R&D au lot final certifié.
Industrie cosmétique : Équilibre efficacité, sensorialité, sécurité et conformité.
Le développement cosmétique nécessite d’équilibrer innovation, expérience utilisateur et exigences réglementaires. Le PLM permet d’ajuster les formules tout en vérifiant la compatibilité des ingrédients et les limites légales (IFRA, ISO, restrictions internationales). L’intégration avec l’ERP assure une planification fluide et un sourcing matières conforme, tandis que la GPAO garantit une exécution fidèle des recettes, préservant texture, sensorialité et performance du produit. Résultat : des lancements rapides, maîtrisés et 100 % conformes.
Industrie agroalimentaire : Optimisation goût, texture, nutrition, stabilité, conservation.
Dans l’agroalimentaire, les formulations doivent répondre à des critères multiples : goût, texture, valeurs nutritionnelles, sécurité sanitaire, conservation et réglementation. Le PLM facilite les ajustements des recettes, les calculs nutritionnels, la gestion des allergènes et la conformité aux normes. L’ERP coordonne les approvisionnements et les stocks sensibles, tandis que la GPAO garantit une traçabilité complète du champ au produit fini. Ainsi, chaque lot est maîtrisé, conforme et reproductible, même dans des environnements à forte variabilité matières.
Industrie chimique & pétrochimique : Formulation haute performance, résistance, stabilité, durabilité.
Les entreprises chimiques et pétrochimiques développent des produits exigeant des caractéristiques hautes performances : résistance thermique, stabilité, longévité, comportement en conditions extrêmes. Le PLM permet d’optimiser les formulations, de simuler les variantes et de gérer les propriétés physico-chimiques avec précision. L’ERP assure la logistique matières à haut risque ou haute sensibilité, tandis que la GPAO pilote des procédés complexes nécessitant des paramètres stricts. Cette intégration assure robustesse, sécurité et conformité réglementaire.
Industrie biopharmaceutique & biotechnologique : Stabilisation des biomédicaments sensibles, intégrité et efficacité garanties.
Les bioproduits, comme les anticorps monoclonaux ou les vaccins, exigent une maîtrise extrême des conditions de formulation et de production. Le PLM facilite la gestion des dossiers complexes, de la stabilité biologique aux conditions de chaîne froide. L’ERP gère les ressources spécialisées, les consommables critiques et leurs cycles de validité, tandis que la GPAO garantit une exécution conforme aux standards BPF et aux protocoles biologiques sensibles. L’intégrité du biomédicament est assurée tout au long du cycle de vie.
Industrie plasturgie & élastomères : Propriétés mécaniques, résistance, flexibilité, performance accrue.
La plasturgie et les élastomères nécessitent une gestion fine des propriétés mécaniques, de la flexibilité, de la résistance chimique et de la performance du matériau. Le PLM permet de comparer variantes et formulations pour atteindre les propriétés recherchées. L’ERP synchronise les flux matières (polymères, charges, additifs), et la GPAO contrôle les paramètres de transformation (températures, pressions, cycles machines). L’intégration des trois systèmes garantit une qualité constante et une optimisation continue des performances matériaux.
PLM + ERP + GPAO – Le Nouveau Triptyque de l’Innovation Industrielle Fiable et Sans Risque
Dans une industrie où les cycles d’innovation se réduisent et où les exigences réglementaires se durcissent, le PLM devient le pivot stratégique pour créer plus vite des produits sûrs, durables et conformes. Mais sa pleine puissance n’émerge que lorsqu’il est relié à l’ERP, à la GPAO/MES, au SCM et à la GMAO, formant un écosystème digital unifié et maîtrisé. Le PLM sécurise toute la création produit : formulation, spécifications, essais, risques, réglementaire et documentation. Il offre aux équipes R&D et qualité un espace unique pour innover de manière traçable, auditable et 100 % conforme dès la conception.
- L’ERP traduit ensuite ces innovations en données économiques et logistiques fiables : nomenclatures, coûts, achats, stocks, planification. Chaque évolution produit est automatiquement synchronisée pour garantir cohérence, efficacité et maîtrise financière.
- La GPAO/MES transforme la conception en production réelle : recettes opératoires, réglages machines, contrôles en cours, traçabilité des lots, réduction des non-conformités. Le PLM définit la vérité produit ; la GPAO assure son exécution fidèle et reproductible.
- Le SCM sécurise l’ensemble en alignant innovation, sourcing et approvisionnements : alternatives matières, qualification fournisseurs, risques géographiques, durabilité. Il protège la chaîne de valeur et limite les dépendances critiques.
- La GMAO garantit enfin la fiabilité des équipements, condition indispensable pour produire en sécurité, en conformité et avec une qualité constante.
L’avenir industriel repose sur un socle simple et puissant : PLM pour concevoir, ERP pour orchestrer, GPAO pour exécuter, SCM pour sécuriser, GMAO pour maintenir. Un modèle où l’innovation cesse d’être un risque pour devenir une avantage compétitif durable.Le SCMLe SCM
